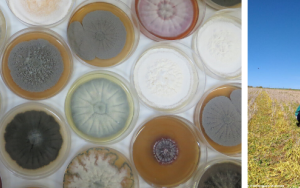
Researchers to uncover intricacies of life in the ‘rhizosphere’

Media release
Wastewater harbours high-risk antimicrobial resistance genes
In South Africa, wastewater treatment plants (WWTPs) and connected river systems could serve as reservoirs of antibiotic resistance, raising fresh concerns...

Media release
New African species confirms evolutionary origin of magic mushrooms
A long-standing debate about the evolutionary origin of the world’s most widely cultivated “magic mushroom” – Psilocybe cubensis – may now have been settled by...


SU’s Faculty of Science awards four joint international degrees
Stellenbosch University's Faculty of Science this week awarded four joint PhD degrees with universities in the United Kingdom, Germany, France, and Italy in...

Award-winning SU spinout company impresses at COP28 with its plastic waste management solution
Stellenbosch University (SU) spinout company Urobo Biotech has established itself as global research leader by presenting at the 28th Conference of the...

Prominent microbiome scientist, Thulani Makhalanyane, joins Stellenbosch University
Stellenbosch University welcomes internationally renowned microbiome researcher Thulani Makhalanyane, who joins the University today (1 November) to take up...

New species of medicinal mushroom endemic to Knysna forest
A new species of medicinal mushroom in the genus Hericium was recently identified by a third-year microbiology and genetics student at Stellenbosch...

Applying your microbiology lab-skills in the wine industry
“My advice would be to keep an open mind. You never really know where you might end up." – Christina Relihan, BSc-graduate in molecular biology and...
Researchers to uncover intricacies of life in the ‘rhizosphere’
A team of researchers are set to uncover the intricacies of life in the 'rhizosphere' after receiving funding from the Foundational Biodiversity Information...
